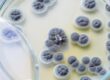

Reviewing and Summarizing the recent Toxic Mold Summit Session by Jeff Bookout Part 2 of 2
(Read this blog series’ introduction at very end if you are catching up. Look for “SERIES INTRODUCTION”)
Jeff Bookout, from Oklahoma EnviroServe Specialists, provided insights from his work as a certified mold inspector. Here are a few take home points from his talk.
- Finding mold in a home requires more than looking for the big black hairy stuff growing on the wall.
- A good mold inspection requires consideration of all the contributors in that particular home.
- Genetics determines which person in a home gets sick and which does not.
- Proper remediation requires removal and containment.
- After remediation, encapsulation of remaining wood materials should be performed.
- There are different mold cleaning and fogging products to use for remediation.
- The HVAC and ductwork systems are critical areas to clean from mold.
- For environments like dorms where complete control is impossible, air purifiers and other means can provide a level of protection.
- Keep it simple to avoid being overwhelmed.
- Control your indoor air quality
Continuing from our last blog we pick up with #6
Taking a step back in the remediation process, Mr. Bookout describes some products used in the cleaning of the remaining building environment. After the moldy materials are removed under containment, various fogging agents and cleaning products are available. Each has different advantage and disadvantages and thus some are more appropriate for different situations than others. He discusses the differences between dry fog and wet fog products. Each have particular strengths depending on what materials are being cleaned and whether the remediated area is a single unit or multi-unit space (like a dorm or office or apartment). Dry fogs are more useful in ductwork but wet fogs may work better to penetrate mattresses. One must also consider if the fogging agent will leave a residue that triggers chemical sensitivities. Thinking through these factors before choosing which product can make or break a remediation process.
Once again considering the remediation process itself, the HVAC system with its ductwork deserves special attention if one wants a clean home again. Having circulated the air and its contaminants countless times, any mold spores present will have settled in the system if not set up new colonies in an HVAC unit where moisture accumulates. Cleaning everything else but leaving the HVAC and its ductwork untouched only leads to a repeat need for remediation. Mr. Bookout discusses different ways to treat and prevent mold in HVAC systems including different fogging products.
Many of our patients discover that their mold exposure originates from sources that they can neither fully remediate or cannot avoid for a period of time. These can be dorm rooms or apartments with leases that would be costly to break. Sometimes colleges will allow moves and will work to clean up a moldy AC unit, but even then the environment may not be ideal. Dorms and apartments can be easily contaminated by a neighbor’s “oops” water accident. In those situations, the use of anti-mold cleaners like essential oils and air purifiers may provide a level of safety until a move can occur. A dehumidifier can lower the humidity to discourage mold growth. An air purifier with a HEPA filter can remove the spores while a carbon filter can remove the toxin load. Controlling dust and using various anti-mold cleaners will sometimes make the environment safe enough for a period with some diligence.
Mold toxic patients come to us often overwhelmed by their illness, due to its duration and severity. The remediation process adds to that sense of being overwhelmed and can lead many to despair. Like Mr. Bookout, we try to keep it as simple as possible without being simplistic. Not only is each patient’s detox regimen a little different based on their needs, but their home’s remediation plan will be different as well. Simple principles and ongoing guidance by our clinical staff go a long way to enable our patients to establish a safe living space. There are a ton of options and products on the mold remediation market. Most present themselves as the best for nearly any situation, but in reality each are better suited for different situations. Having a remediator with a variety of “remediating detox tools” that he or she can apply based on your unique situation will be more successful than one who over-relies on one product alone.
Their goal beyond the removal of mold already present is to establish control of the air quality in your home and enable you to maintain that control. If control is never established or you are unable to maintain that control, the long term safety of the environment will never be achieved. We want a safe home for decades, not just a few days or weeks of a mold free living space. A life free of mold is our goal.
References
AFM Safecoat Site https://www.afmsafecoat.com/
We have not tried these but plan to do so in near future. (UPDATE: A close remediator friend reports that they release more VOC’s than expected)
Fogging Agents
MDF information: https://greensolpro.com/about-mdf-500%C2%AE
My family has used this for both remediation and prevention (during new home construction). I am confident in its effectiveness when used correctly.
US Enzymes: Natural Mold Products: https://usenzyme.com/shop/ My family has also used these products and have confidence in them.
EC3 product line: https://microbalancehealthproducts.com/Mold-Products?rfsn=1018830.ca4fb
My family tried their mold candles but were not impressed. I know many who used other products with reported success however.
Essential Oil products: Several different individual oils and combinations of these oils have been shown to lower mold growth and or toxins. We recommend the Close Protocol as additional measure after remediation of visible mold. The site for this is here http://www.naturesmoldrx.com/
A guide for use of cold oil diffusers is here: http://www.naturesmoldrx.com/p/blog-page.html
My favorite diffuser (workhorse which has been great for my family): https://store.diffuserworld.com/Aroma-Ace%E2%84%A2-Essential-Oil-Atomizing-Diffuser-110V-US-_p_12.html Just don’t tip it over allowing oil to enter diffuser from chamber.. will ruin diffuser.
Indoor Air Quality Association: http://www.iaqa.org/
ARTICLES
Essential Oils
Nazzaro, Filomena et al. “Essential Oils and Antifungal Activity.” Pharmaceuticals (Basel, Switzerland) vol. 10,4 86. 2 Nov. 2017, doi:10.3390/ph10040086
Thanks to those who collaborated and contributed to the Toxic Mold Summit. While I have a few nuanced different opinions here and there, the information one can glean from listening to this summit is empowering for those facing this disease. While some are able to handle the recovery process without formal care by a medical provider, I do believe it is wise for most to have a “trusted guide” of some sort who stands outside the tornado of active mold toxicity. Standing inside the mold tornado leaves one with a spinning sense of direction. Having a stable and fixed point of reference in a knowledgeable guide serves you well. Traveling the road to recovery is better done with someone who has walked it before. That is what we try to do at Sanctuary is working to restore healthier more abundant lives even after the tornado of mold toxicity.
To order the Summit from our affiliate link, click here (we receive a commission for this purchase): https://toxicmoldproject.com/order/?idev_id=25016
SERIES INTRODUCTION
You may feel a little overwhelmed and stressed after the recent Toxic Mold Summit A great line up of both clinical types and environmental remediator types took the stage for several day offering a smorgasbord of information about mold toxicity. Now, what do you do with all that information? Should you run out the door screaming in your underwear and leave everything behind?
Short answer….NO! You should simply keep coming back to Sanctuary’s Facebook Live sessions every other week about mold toxicity and read our regular blog posts about mold toxicity and a ton of other chronic health issues. Bring your questions. Hear from myself, Dr. Eric Potter Functional MD who has walked both sides of the mold toxicity line in caring for my family and for hundreds of patients. While I can’t diagnose or treat non-patients by Facebook, I will do my best to educate and empower you in the journey of healing from mold toxicity. Over the coming weeks, I will review several of the Mold Summit’s sessions with additional information from our experience and study.)
Sanctuary Functional Medicine, under the direction of Dr Eric Potter, IFMCP MD, provides functional medicine services to Nashville, Middle Tennessee and beyond. We frequently treat patients from Kentucky, Alabama, Mississippi, Georgia, Ohio, Indiana, and more... offering the hope of healthier more abundant lives to those with chronic illness.

Dr. Eric Potter graduated from Vanderbilt Medical School and then went on to specialize in internal medicine (adult) and pediatric care, spending significant time and effort in growing his medical understanding while caring for patients from all walks of life.

I have been involved in the remediation field for a few years now and have learned a lot. I have also been involved in researching and developing non-toxic remediation methods.
Non-toxic remediation technologies can help protect people, the environment, and businesses from harmful environmental toxins. These technologies can remove oil and gas spills, contaminated soil, PCBs, and more. Non-toxic remediation is a safe and effective way to clean up environmental contamination.